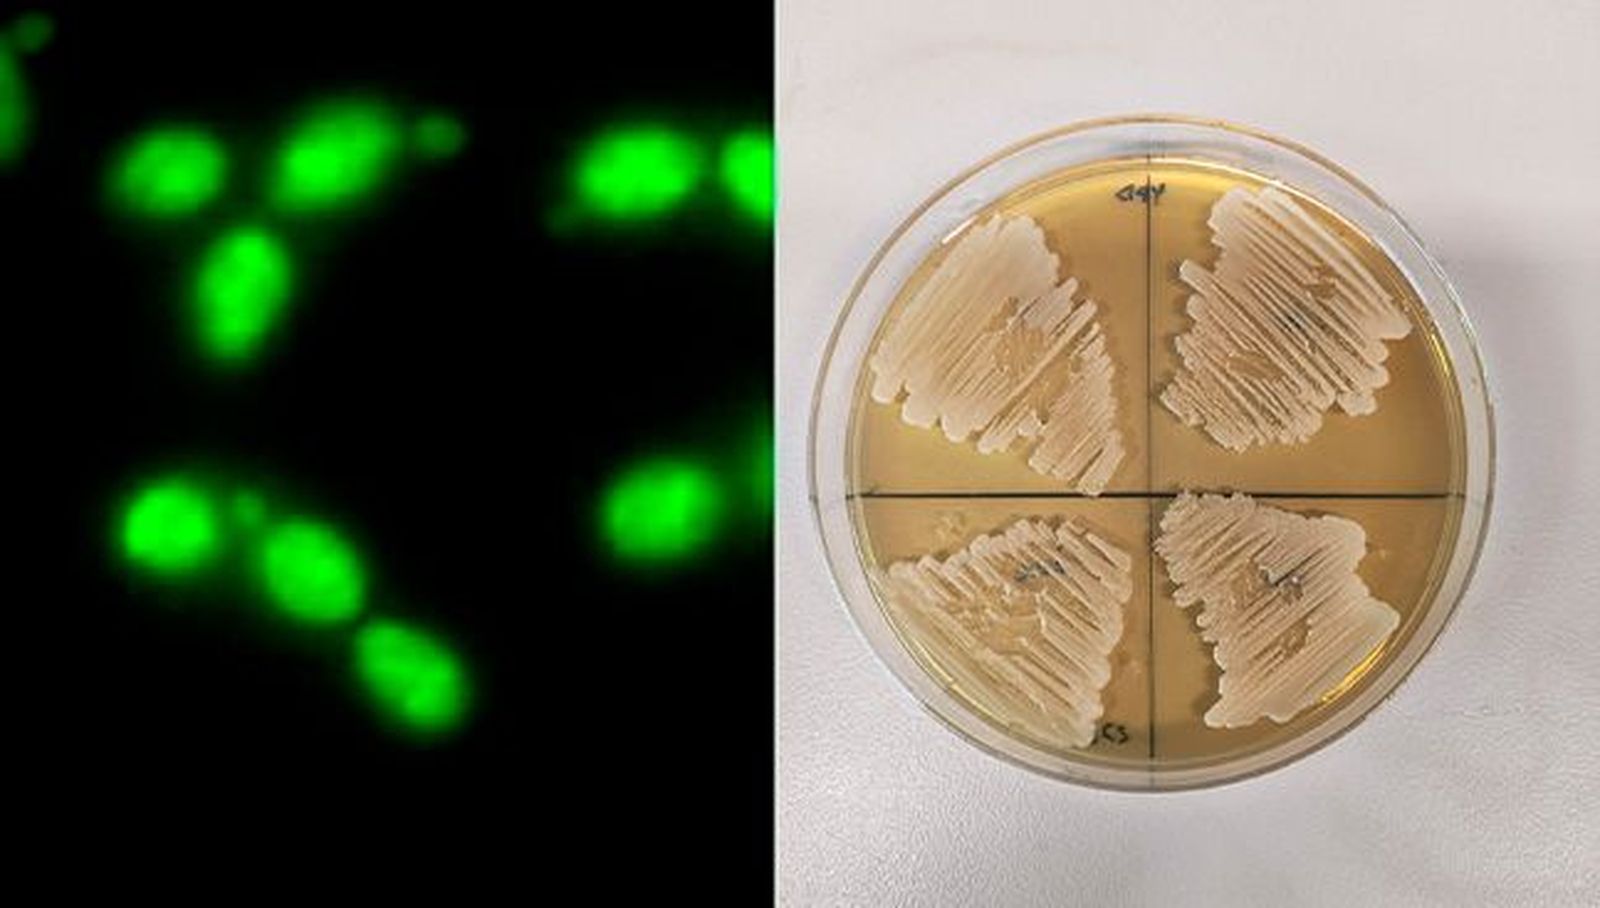
Cepa de estudio C. albicans en placa

La Universidad de Salamanca avanza en el estudio de Candida albicans, principal causa de infección fúngica en hospitales
El microbiólogo de la USAL Víctor Arribas estudia nuevas dianas terapéuticas para el desarrollo de tratamientos antifúngicos en colaboración con la Universidad Complutense de Madrid

Candida albicans es un patógeno oportunista que forma parte de la microbiota de la piel, el intestino y las mucosas. En individuos inmunocomprometidos puede causar candidiasis invasiva, una infección potencialmente mortal que sigue siendo la principal causa de infección fúngica en hospitales. Esta micosis oportunista afecta significativamente a pacientes con cáncer, postoperatorios y en cuidados intensivos, generando costos considerables en la atención médica. Sin embargo, el tratamiento de la candidiasis invasiva está obstaculizado por la limitada disponibilidad de medicamentos antifúngicos y el desarrollo de mecanismos de resistencia a estos fármacos.
En este contexto de urgente necesidad de descubrir dianas terapéuticas para el desarrollo de nuevos antifúngicos, la Universidad de Salamanca y la Universidad Complutense de Madrid desarrollan en colaboración el estudio “Unravelling the Role of Candida albicans Prn1 in the Oxidative Stress Response through a Proteomics Approach”, que revela la importancia de la proteína Prn1 en la respuesta al estrés oxidativo de Candida albicans y cómo en ausencia de la proteína aumenta la apoptosis o muerte celular programada en el microorganismo.
Los resultados del trabajo, recogido en la publicación “Antioxidants” de la editorial de revistas científicas de acceso abierto MDPI, indican que “Prn1 podría ser considerada a estudio como una posible diana terapéutica en el desarrollo de nuevos tratamientos antifúngicos”, explica Arribas a Comunicación USAL.
Cuando la proteína está ausente, las células “tienen más dificultades para combatir el daño causado y son más propensas a morir por una agente oxidante como el peróxido de hidrógeno (agua oxigenada), que es el producido por las células del sistema inmunitario como los macrófagos”. En palabras del científico, “esto sugiere que esta proteína es esencial para proteger a la célula de daños oxidativos y mantener su supervivencia cuando son atacadas por el sistema inmune”.

Comprendiendo el proteoma de C. albicans
El proyecto de investigación, de dos años de duración, fue ejecutado en colaboración del grupo de investigación del Departamento de Microbiología y Parasitología dirigido por la Dra. Concha Gil, catedrática de la Universidad Complutense de Madrid (UCM), y con la Unidad de Proteómica del CAI de Técnicas Biológicas de la misma universidad.
Concretamente, el trabajo se centró en el estudio de la respuesta de C. albicans frente a los macrófagos “mediante técnicas de proteómica diferencial que ayudaran a comprender con mayor precisión los cambios en el proteoma de C. albicans después de la interacción con los mismos”, subraya Arribas.
Para ello, dispusieron de técnicas microbiológicas para estudiar el fenotipo de las células de C. albicans que no tienen la proteína Prn1 cuando se las expone al estrés oxidativo que produce el agua oxigenada (que imita la acción oxidante de las células del sistema inmunitario como los macrófagos).
Además, en colaboración con la Unidad de Citometría de Flujo y Microscopia de Fluorescencia de la UCM, se emplearon técnicas de cultivo y la citometría de flujo para determinar la muerte celular de las células de C. albicans en respuesta al agente oxidante y se utilizó, también, la microscopía de fluorescencia para determinar presencia de agentes oxidantes en el interior celular.
Para el estudio de la expresión diferencial de las proteínas de estas células mutantes sin la proteína Prn1, la principal metodología utilizada fue la espectrometría de masas que “nos ayudó a determinar la abundancia relativa de las proteínas dentro de la célula en presencia y ausencia del agua oxigenada”, indica.
Función de Prn1 en hongos
Prn1 es una proteína con similitud a la pirina en mamíferos, sin embargo, “se desconocía su función en hongos y cómo la ausencia de esta proteína produce una menor respuesta antioxidante a peróxido de hidrógeno”.
Además, el estudio ha permitido al equipo identificar en C. albicans la proteína orf19.4850 (ortóloga de la proteína Cub1 de la levadura S. cerevisiae), sin papel asignado hasta entonces en la respuesta antioxidante y de la que también se desconocía su relación con la expresión de Prn1, pudiendo describir ahora su importancia.
No obstante, lo principal del trabajo es que “se demuestra la importante función de Prn1 en la respuesta a estrés oxidativo en C. albicans, por lo que puede ser una diana para antifúngicos, ya que, si no está presente, la levadura es más sensible al estrés oxidativo”, refiere el investigador de la USAL.
Próximos estudios
La proteína Prn1 presenta dos dominios pirina en su estructura a través de los que los investigadores presumen que, probablemente, realice su función antioxidante en la célula, aunque el mecanismo exacto mediante el que se realiza se desconoce totalmente. Por ello, los próximos estudios del grupo irán encaminados a descifrarlo.
Cabe destacar que, en C. albicans, la proteína Prn1 posee 3 proteínas homólogas (Prn2, Prn3 y Prn4) con una elevada similitud con ésta y cuyas funciones también podrían estar implicadas en la respuesta a agentes oxidantes, especialmente cuando la función de Prn1 está ausente, “aunque no parece que sean capaces, ninguna de ellas, de suplir la falta de Prn1 en la levadura cuando hay estrés oxidativo. Por ello es de vital importancia conocer el papel exacto de estas proteínas”.
Asimismo, mediante nuevos estudios de proteómica, los investigadores enfocarán los futuros trabajos a identificar nuevas proteínas esenciales en la respuesta a agentes oxidantes.
Amenaza de las infecciones fúngicas
El descubrimiento de nuevos antifúngicos es de suma importancia debido a la creciente amenaza de las infecciones fúngicas, especialmente en poblaciones vulnerables. Además, a medida que aumenta la resistencia a los antifúngicos existentes es crucial desarrollar nuevas terapias que sean efectivas contra una amplia gama de cepas fúngicas.
Prn1 es una proteína que se encuentra principalmente en hongos patógenos como Candida albicans o Aspergillus nidulans. Así, “el conocimiento de los sistemas que estos hongos patógenos poseen para sobrevivir al ataque del sistema inmunitario es esencial para el descubrimiento de nuevas dianas para el desarrollo de nuevos antifúngicos”, concluye el investigador.
Contrato ‘Margarita Salas’ y financiación
Víctor Arribas realizó el proyecto de investigación en el Departamento de Microbiología y Parasitología de la Universidad Complutense de Madrid, dentro del grupo de investigación de la Dra. Concha Gil. El científico de la Universidad de Salamanca participó en su desarrollo en el marco de su estancia en el departamento con motivo de su contrato “Margarita Salas”. La duración del proyecto fue de 2 años, la extensión del contrato.
El estudio fue financiado por un proyecto a cargo del Ministerio de Ciencia e Innovación de España. El contrato de Víctor Arribas fue apoyado por un contrato de investigación de la Universidad de Salamanca a través del Fondo Europeo NextGenerationEU y el Ministerio de Universidades de España "Ayudas para la recualificación del Sistema Universitario Español, modalidad Margarita Salas 2021-2022".
También te puede interesar
Lo último








